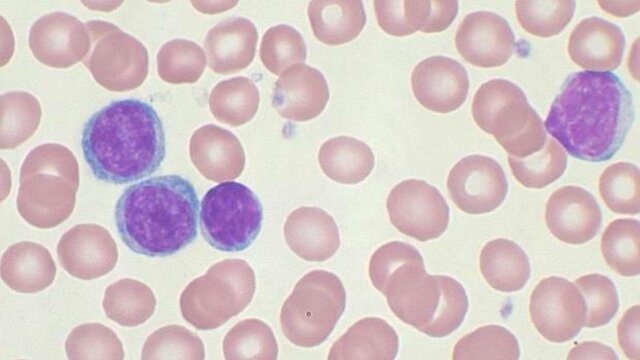
Primera Secuencia Del Genoma Cancer

-
 Karl Ereky: nació el 20 de octubre de 1878 en Esztergom. fue un ingeniero agrícola húngara. el proyecto una era en la que Señaló el proceso de mejora biológica de las materias primas en productos socialmente útiles a través de la evolución del ADN del cerdo, dándose cuenta de la evolución del cerdo, que tiene más grasa. Fue el primero en usar la palabra biotecnología Ereky murió el 17 de junio de 1952 en Vac a la edad de 71 años tras ser encarcelado por participar en la contrarrevolución
Karl Ereky: nació el 20 de octubre de 1878 en Esztergom. fue un ingeniero agrícola húngara. el proyecto una era en la que Señaló el proceso de mejora biológica de las materias primas en productos socialmente útiles a través de la evolución del ADN del cerdo, dándose cuenta de la evolución del cerdo, que tiene más grasa. Fue el primero en usar la palabra biotecnología Ereky murió el 17 de junio de 1952 en Vac a la edad de 71 años tras ser encarcelado por participar en la contrarrevolución -
 Nació el 28 de enero de 1922 en Urbana. Fue un biólogo norteamericano. determino la composición del ARN de transferencia que integra el aminoácido alanina en la molécula de proteína. fue la primera determinación de la secuencia de nucleótidos en un ácido nucleico. uso enzimas para digerir la molécula, identificar los fragmentos y luego analizar cómo encajan. demostró que todos los ARN de transferencia tienen estructuras similares. gano el premio nobel y falleció el 11 de febrero de 1993.
Nació el 28 de enero de 1922 en Urbana. Fue un biólogo norteamericano. determino la composición del ARN de transferencia que integra el aminoácido alanina en la molécula de proteína. fue la primera determinación de la secuencia de nucleótidos en un ácido nucleico. uso enzimas para digerir la molécula, identificar los fragmentos y luego analizar cómo encajan. demostró que todos los ARN de transferencia tienen estructuras similares. gano el premio nobel y falleció el 11 de febrero de 1993. -
 nació el 9 de enero de 1922 en Pakistán. Fue un científico bioquímico que estaba muy interesado en el como desde los ácidos nucleicos la información genética fluye hasta las proteínas y la realización y regulación de las células. También descubrió las asignaciones del código genético para distintos aminoácidos y sintetizó, artificialmente, un gen por primera vez. Gracias a esto consiguió el permio nobel de medicina y fisiología. Murió el 9 de noviembre del 2011 por causas naturales.
nació el 9 de enero de 1922 en Pakistán. Fue un científico bioquímico que estaba muy interesado en el como desde los ácidos nucleicos la información genética fluye hasta las proteínas y la realización y regulación de las células. También descubrió las asignaciones del código genético para distintos aminoácidos y sintetizó, artificialmente, un gen por primera vez. Gracias a esto consiguió el permio nobel de medicina y fisiología. Murió el 9 de noviembre del 2011 por causas naturales. -
 Stanley Norman Cohen nació en 30 de junio de 1935 en new york, USA. Herbert Boyer nació el 10 de julio de 1936 en Pensilvania USA. Estos genistas desarrollaron la tecnología de ADN recombinante, una metodología para unir artificialmente fragmentos de ADN (ácido desoxirribonucleico) que no se encuentran juntos en la naturaleza. Esa técnica es la recombinación genética.
Stanley Norman Cohen nació en 30 de junio de 1935 en new york, USA. Herbert Boyer nació el 10 de julio de 1936 en Pensilvania USA. Estos genistas desarrollaron la tecnología de ADN recombinante, una metodología para unir artificialmente fragmentos de ADN (ácido desoxirribonucleico) que no se encuentran juntos en la naturaleza. Esa técnica es la recombinación genética. -
 En 1976, logró que el gen funcionara en células vivas. Por este descubrimiento, ya sea el desarrollo de la ingeniería genética o el desarrollo de la industria biotecnológica, se le atribuye, porque prueba la posibilidad de sintetizar fragmentos cortos de ADN.
En 1976, logró que el gen funcionara en células vivas. Por este descubrimiento, ya sea el desarrollo de la ingeniería genética o el desarrollo de la industria biotecnológica, se le atribuye, porque prueba la posibilidad de sintetizar fragmentos cortos de ADN. -
 Boyer anteriormente había contribuido al desarrollo del ADN recombinante, cosa que le intereso a Swanson y decidió llamar a Boyer para solicitarle una reunión. Boyer acepto y decidió darle a Swanson 10 minutos de su tiempo, la reunión inicio y de lo que inicialmente eran 10 minutos termino en 3 horas. Gracias a todos los acuerdos de esta reunión nación Genentech corporación líder en tecnología y considerada la compañía que fundo la industria de la biotecnología
Boyer anteriormente había contribuido al desarrollo del ADN recombinante, cosa que le intereso a Swanson y decidió llamar a Boyer para solicitarle una reunión. Boyer acepto y decidió darle a Swanson 10 minutos de su tiempo, la reunión inicio y de lo que inicialmente eran 10 minutos termino en 3 horas. Gracias a todos los acuerdos de esta reunión nación Genentech corporación líder en tecnología y considerada la compañía que fundo la industria de la biotecnología -
 La idea consistía en extraer un ovulo, fertilizarlo en el laboratorio con el esperma del hombre, y después de que se formara el embrión, este se introdujese en el útero materno. Patrick Steptoe y Robert Edwards fueron los doctores encargados de esto y al final se consiguió el nacimiento de Louise Brown el 25 de julio de 1978.
La idea consistía en extraer un ovulo, fertilizarlo en el laboratorio con el esperma del hombre, y después de que se formara el embrión, este se introdujese en el útero materno. Patrick Steptoe y Robert Edwards fueron los doctores encargados de esto y al final se consiguió el nacimiento de Louise Brown el 25 de julio de 1978. -
 Primer diagnóstico prenatal de una enfermedad humana por medio del análisis del ADN.al primer diagnóstico prenatal de aberraciones cromosómicas y al primer diagnóstico de un trastorno metabólico hereditario
Primer diagnóstico prenatal de una enfermedad humana por medio del análisis del ADN.al primer diagnóstico prenatal de aberraciones cromosómicas y al primer diagnóstico de un trastorno metabólico hereditario -
 Se produjo la primera insulina obtenida por la técnica de ADN recombinante, antes de esto, en las personas con diabetes se usaba la insulina porcina que como su nombre lo indica se conseguía de los cerdos, cosa que traía dificultades en su producción. La insulina humana fue la primera proteína producida por biotecnología y se generó tras la reproducción y extracción de un gen con la información para fabricar esta hormona.
Se produjo la primera insulina obtenida por la técnica de ADN recombinante, antes de esto, en las personas con diabetes se usaba la insulina porcina que como su nombre lo indica se conseguía de los cerdos, cosa que traía dificultades en su producción. La insulina humana fue la primera proteína producida por biotecnología y se generó tras la reproducción y extracción de un gen con la información para fabricar esta hormona. -
 Mediante la microinyección. Los genes introducidos se dieron en organismos que desarrollan óvulos. Jon Gordon y Frank Ruddle tomaron la iniciativa de insertar secuencias de ADN en óvulos de ratón fertilizados. Ralph Brinster y Richard Palmiter combinaron el gen de la hormona del crecimiento humano con la parte reguladora del gen del ratón y lo inyectaron en el óvulo del ratón. Los ratones transgénicos crecieron el doble de lo normal, indicando que los genes produjeron la hormona del crecimiento.
Mediante la microinyección. Los genes introducidos se dieron en organismos que desarrollan óvulos. Jon Gordon y Frank Ruddle tomaron la iniciativa de insertar secuencias de ADN en óvulos de ratón fertilizados. Ralph Brinster y Richard Palmiter combinaron el gen de la hormona del crecimiento humano con la parte reguladora del gen del ratón y lo inyectaron en el óvulo del ratón. Los ratones transgénicos crecieron el doble de lo normal, indicando que los genes produjeron la hormona del crecimiento. -
 se dio la primera planta transgénica las cuales mediante técnicas genéticas se les introducen genes de otra especie vegetal, animal o bacteriana, dotándose de alguna cualidad, en esta época se logró con la bacteria Escherichia Coli y se aprobaron estos alimentos producidos por la empresa Calgene.
se dio la primera planta transgénica las cuales mediante técnicas genéticas se les introducen genes de otra especie vegetal, animal o bacteriana, dotándose de alguna cualidad, en esta época se logró con la bacteria Escherichia Coli y se aprobaron estos alimentos producidos por la empresa Calgene. -
 Al científico Kary Mullis se le ocurrió durante un viaje nocturno es su auto que al unir dos oligonucleótidos en hebras opuestas del ADN estos podrían amplificar el fragmento contenido entre ambos. Para poner en practica esto dio con la idea de usar el calor para separar las dobles cadenas ya creadas y así consiguió crear la técnica de PCR.
Al científico Kary Mullis se le ocurrió durante un viaje nocturno es su auto que al unir dos oligonucleótidos en hebras opuestas del ADN estos podrían amplificar el fragmento contenido entre ambos. Para poner en practica esto dio con la idea de usar el calor para separar las dobles cadenas ya creadas y así consiguió crear la técnica de PCR. -
 Alee Jeffreys y sus colaboradores propusieron una nueva manera para identificar personas y establecer relaciones de parentesco, extrayendo ADN, cortarlo y separarlo en un campo eléctrico, se saca una pequeña porción del ADN del genoma que lleva una variable del individuo y como resultado final una serie de bandas que son únicas en las personas. El caso en el que se uso fue en el asesinato y violación de dos mujeres, y gracias a esta técnica se logro comprobar la culpabilidad del asesino.
Alee Jeffreys y sus colaboradores propusieron una nueva manera para identificar personas y establecer relaciones de parentesco, extrayendo ADN, cortarlo y separarlo en un campo eléctrico, se saca una pequeña porción del ADN del genoma que lleva una variable del individuo y como resultado final una serie de bandas que son únicas en las personas. El caso en el que se uso fue en el asesinato y violación de dos mujeres, y gracias a esta técnica se logro comprobar la culpabilidad del asesino. -
 : La vacuna fue desarrollada por el bioquímico chileno Pablo Valenzuela quien inicio con la curiosidad a estudiar el organismo de la levadura panificadora, luego secuencio la información genética del virus de la hepatitis b y con estos elementos Inserto un trozo de ADN dentro de la levadura, de tal manera que ésta creía que era un pedazo de su mini cromosoma y así expresó la proteína que esa información le entregaba. Finalmente, esta vacuna fue aprobada
: La vacuna fue desarrollada por el bioquímico chileno Pablo Valenzuela quien inicio con la curiosidad a estudiar el organismo de la levadura panificadora, luego secuencio la información genética del virus de la hepatitis b y con estos elementos Inserto un trozo de ADN dentro de la levadura, de tal manera que ésta creía que era un pedazo de su mini cromosoma y así expresó la proteína que esa información le entregaba. Finalmente, esta vacuna fue aprobada -
 el experimento fue realizado por French Anderson y Michael Biaese en unan niña de cuatro años con la enfermedad ADA, y esta terapia consiste en introducir en la sangre de la niña unas células defectuosas extraídas previamente de ella misma, pero corregidas y multiplicadas en laboratorio por técnicas de ingeniería genética.
el experimento fue realizado por French Anderson y Michael Biaese en unan niña de cuatro años con la enfermedad ADA, y esta terapia consiste en introducir en la sangre de la niña unas células defectuosas extraídas previamente de ella misma, pero corregidas y multiplicadas en laboratorio por técnicas de ingeniería genética. -
 El primero de octubre de 1990 el Instituto Nacional de Salud y el Departamento de Energía de los Estados Unidos, informaron el lanzamiento del Proyecto Genoma Humano y nombran a James Watson director del Centro Nacional de Investigación del Genoma Humano. Los objetivos de esto eran la elaboración de mapas genéticos y físicos, desarrollar nuevas tecnologías, analizaría y debatiría implicaciones para los individuos y sociedad, etc. Se dijo que culminaría en 2005 y usaría 300 millones de dólares.
El primero de octubre de 1990 el Instituto Nacional de Salud y el Departamento de Energía de los Estados Unidos, informaron el lanzamiento del Proyecto Genoma Humano y nombran a James Watson director del Centro Nacional de Investigación del Genoma Humano. Los objetivos de esto eran la elaboración de mapas genéticos y físicos, desarrollar nuevas tecnologías, analizaría y debatiría implicaciones para los individuos y sociedad, etc. Se dijo que culminaría en 2005 y usaría 300 millones de dólares. -
 los científicos lograron trazar el mapa genético completo de la levadura. Este organismo unicelular se usa para producir cerveza, biocombustible y medicinas. Este logro supone un gran paso en el campo de la biología sintética que permitirá el diseño de microorganismos para producir nuevos medicamentos, materias primas para la alimentación y biocombustibles.
los científicos lograron trazar el mapa genético completo de la levadura. Este organismo unicelular se usa para producir cerveza, biocombustible y medicinas. Este logro supone un gran paso en el campo de la biología sintética que permitirá el diseño de microorganismos para producir nuevos medicamentos, materias primas para la alimentación y biocombustibles. -
 los científicos Ian Wilmut y Keith Campbell usaron una célula de una glándula mamaria de una oveja. como era una célula adulta se trataba de una célula incapaz de actuar como célula indiferenciada, se consideraba que cuando una célula desarrolla la parte del genoma que no necesita es inactivado irreversiblemente. pero, al cultivar células mamarias en un medio bajo en nutrientes activaban sus genes actuando como células totipotentes. Dolly nació en el Instituto Roslin de Escocia el 5 de julio.
los científicos Ian Wilmut y Keith Campbell usaron una célula de una glándula mamaria de una oveja. como era una célula adulta se trataba de una célula incapaz de actuar como célula indiferenciada, se consideraba que cuando una célula desarrolla la parte del genoma que no necesita es inactivado irreversiblemente. pero, al cultivar células mamarias en un medio bajo en nutrientes activaban sus genes actuando como células totipotentes. Dolly nació en el Instituto Roslin de Escocia el 5 de julio. -
 El 14 de abril de 2003, el Consorcio Internacional para la Secuenciación del Genoma Humano anuncio que estaba completa la secuencia con una confiabilidad del 99, 9%. El proyecto terminó dos años antes de la fecha que se tenía estipulada, el costo total del proyecto fue 2700 millones. Se conoció que el genoma contiene 3x109 pares de bases y aproximadamente 25.000 genes, muy por debajo de las expectativas que se tenían de 50.000 a 100.000 genes.
El 14 de abril de 2003, el Consorcio Internacional para la Secuenciación del Genoma Humano anuncio que estaba completa la secuencia con una confiabilidad del 99, 9%. El proyecto terminó dos años antes de la fecha que se tenía estipulada, el costo total del proyecto fue 2700 millones. Se conoció que el genoma contiene 3x109 pares de bases y aproximadamente 25.000 genes, muy por debajo de las expectativas que se tenían de 50.000 a 100.000 genes. -
 En el año 2005, científicos de la Universidad de Harvard reportan haber tenido éxito en convertir células de piel en células troncales embrionarias al fusionarlas con células troncales embrionarias existentes lo que conduce a la creación de una célula híbrida. Esta célula, en un principio, tiene el ADN de la persona que ha donado la célula de su piel y también el ADN que estaba inicialmente en la célula embrionaria fusionada.
En el año 2005, científicos de la Universidad de Harvard reportan haber tenido éxito en convertir células de piel en células troncales embrionarias al fusionarlas con células troncales embrionarias existentes lo que conduce a la creación de una célula híbrida. Esta célula, en un principio, tiene el ADN de la persona que ha donado la célula de su piel y también el ADN que estaba inicialmente en la célula embrionaria fusionada. -
Un equipo de investigadores secuenció un genoma específico de una mujer que murió de leucemia mieloide aguda y encontró mutaciones en 10 genes específicos. En las últimas décadas, según diversas estrategias basadas en tecnologías de secuenciación tradicionales, identificaron genes implicados en el desarrollo tumoral. Aunque en algunos estudios se han secuenciado grandes áreas de ADN, son insuficientes para resolver la complejidad mutacional general del cáncer.
Un equipo de investigadores secuenció un genoma específico de una mujer que murió de leucemia mieloide aguda y encontró mutaciones en 10 genes específicos. En las últimas décadas, según diversas estrategias basadas en tecnologías de secuenciación tradicionales, identificaron genes implicados en el desarrollo tumoral. Aunque en algunos estudios se han secuenciado grandes áreas de ADN, son insuficientes para resolver la complejidad mutacional general del cáncer. -
 El Hospital Universitario Valle de Hebron en Barcelona, España, anunció que completaron con éxito el primer trasplante de rostro completo del mundo. Lo realizo un equipo de 25 expertos al mando del doctor Dr. Joan Pere Barret, el 20 de marzo con duración de 30 horas. El paciente era un joven con deformidades faciales que le impedían respirar bien. La obtención de tejido facial del donante finaliza con la reconstrucción de su rostro en forma de máscara, que es una réplica de su propio rostro.
El Hospital Universitario Valle de Hebron en Barcelona, España, anunció que completaron con éxito el primer trasplante de rostro completo del mundo. Lo realizo un equipo de 25 expertos al mando del doctor Dr. Joan Pere Barret, el 20 de marzo con duración de 30 horas. El paciente era un joven con deformidades faciales que le impedían respirar bien. La obtención de tejido facial del donante finaliza con la reconstrucción de su rostro en forma de máscara, que es una réplica de su propio rostro. -
 Un total de 28 países cultivaron semillas MG en 2012. De éstos 20 fueron países en vías de desarrollo y 8 eran industrializados. En estos 28 países viven aproximadamente el 60% de la población mundial (4 mil millones de personas). Sudán y Cuba plantaron por primera vez semillas MG.
Un total de 28 países cultivaron semillas MG en 2012. De éstos 20 fueron países en vías de desarrollo y 8 eran industrializados. En estos 28 países viven aproximadamente el 60% de la población mundial (4 mil millones de personas). Sudán y Cuba plantaron por primera vez semillas MG. -
 El desarrollo de células microbianas que utilizan hidrocarburos a la vez que generan energía para el uso humano en la recuperación de suelos y aguas contaminadas con estos hidrocarburos, por el grupo de investigación liderado por Zhiyong Ren en EE.UU. a inicios de 2014.
El desarrollo de células microbianas que utilizan hidrocarburos a la vez que generan energía para el uso humano en la recuperación de suelos y aguas contaminadas con estos hidrocarburos, por el grupo de investigación liderado por Zhiyong Ren en EE.UU. a inicios de 2014. -
 Varios investigadores consiguieron rastrear el primer gen relacionado con el pelo canoso, dando alas a la teoría de que el envejecimiento es, de hecho, genético. El gen, denominado IRF4, fue localizado en un análisis detallado de los genomas y colores de pelo de más de 6.000 personas en cinco países de América Latina. Con posteriores estudios, el descubrimiento podría conducir a medicamentos para ayudar a prevenir o incluso acelerar el encanecimiento.
Varios investigadores consiguieron rastrear el primer gen relacionado con el pelo canoso, dando alas a la teoría de que el envejecimiento es, de hecho, genético. El gen, denominado IRF4, fue localizado en un análisis detallado de los genomas y colores de pelo de más de 6.000 personas en cinco países de América Latina. Con posteriores estudios, el descubrimiento podría conducir a medicamentos para ayudar a prevenir o incluso acelerar el encanecimiento. -
 un grupo de investigadores ha publicado un estudio en el que caracterizan la estructura y el funcionamiento de bacterias capaces de descomponer el plástico. El origen de estas investigaciones se remonta a 2016, cuando un equipo de científicos japoneses descubrió la Ideonella sakaiensis, una bacteria existente en vertederos que utiliza los residuos PET como combustible energético. Esto para ayudar a frenar la contaminación del plástico.
un grupo de investigadores ha publicado un estudio en el que caracterizan la estructura y el funcionamiento de bacterias capaces de descomponer el plástico. El origen de estas investigaciones se remonta a 2016, cuando un equipo de científicos japoneses descubrió la Ideonella sakaiensis, una bacteria existente en vertederos que utiliza los residuos PET como combustible energético. Esto para ayudar a frenar la contaminación del plástico. -
 A la ciencia y a los científicos les tomó apenas 42 días estar en la primera fase clínica de una vacuna basada en biotecnología moderna.La vacuna se llama mRNA-1273 de la compañía Moderna Therapeutics, y codifica para un fragmento de la cubierta del virus (CoV spike), quizá el fragmento más importante pues es la llave de ingreso a las células humanas.
A la ciencia y a los científicos les tomó apenas 42 días estar en la primera fase clínica de una vacuna basada en biotecnología moderna.La vacuna se llama mRNA-1273 de la compañía Moderna Therapeutics, y codifica para un fragmento de la cubierta del virus (CoV spike), quizá el fragmento más importante pues es la llave de ingreso a las células humanas. -
 actualmente en 2021 se siguen desarrollando muchas vacunas contra el COVID 19 tales como Vacunas con ARN y ADN: un enfoque pionero que utiliza ARN o ADN genéticamente modificados para generar una proteína que por sí sola desencadena una respuesta inmunitaria. Vacunas basadas en proteínas: utilizan fragmentos inocuos de proteínas o estructuras proteínicas que imitan el virus causante de la COVID-19, con el fin de generar una respuesta inmunitaria. etc.
actualmente en 2021 se siguen desarrollando muchas vacunas contra el COVID 19 tales como Vacunas con ARN y ADN: un enfoque pionero que utiliza ARN o ADN genéticamente modificados para generar una proteína que por sí sola desencadena una respuesta inmunitaria. Vacunas basadas en proteínas: utilizan fragmentos inocuos de proteínas o estructuras proteínicas que imitan el virus causante de la COVID-19, con el fin de generar una respuesta inmunitaria. etc.
Want to make a timeline like this?
Use Timetoast to turn dates, events, milestones, and phases into a clear visual timeline you can build and share. Timetoast is a timeline maker for work, school, research, and stories.
